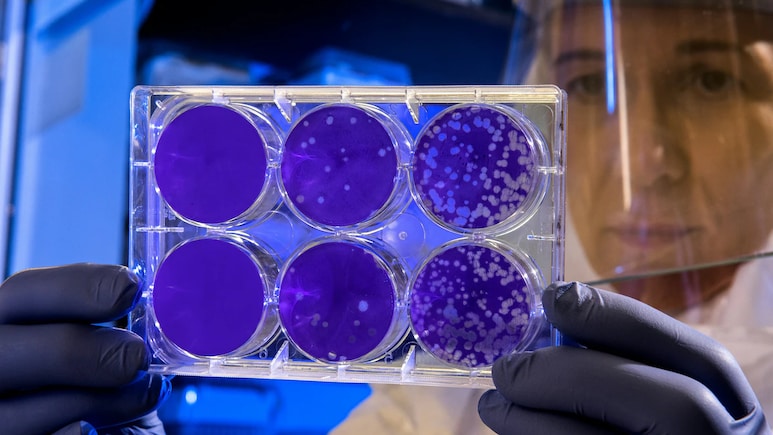
New COVID-19 Variant 'Cicada' Detected In 22 Countries: What We Know

The COVID-19 memories have surfaced again as a new variant has sparked fresh concern. Amid growing COVID-style lockdown rumours due to the LPG crisis, a new strain has been detected.
The latest variant of the COVID-19 virus has been observed in approximately 22 countries worldwide, including the USA, and is noted for possessing a significant number of mutations, thereby attracting considerable attention from public health authorities globally, according to recent monitoring reports seen by India Today. Scientists have designated the variant as Covid-19 BA.3.2, which has been detected in nearly half of the states within the USA, as well as about 21 other nations.
Also Read: WFH To Air Travel Curbs: Asia Revives Covid-Era Playbook As Iran War Triggers Fuel Crisis
Why is the new strain named ‘Cicada'?
This new COVID-19 variant has been colloquially named "Cicada," after an insect that emerges after a lengthy period underground. Although COVID-19 has been largely managed through vaccination efforts, there are emerging indications that the virus is becoming active once more. This variant was first recognised in South Africa in November 2024 but went unnoticed for an extended duration.
Initial evaluations have suggested that nearly 75 mutations are believed to be present in the “Cicada” variant, which is twice the amount found in earlier variants like JN.1.
First case of the new COVID strain
The BA.3.2 was first detected in November 2024 from a respiratory sample taken in South Africa. For several months, a few cases were noted in genomic databases, and throughout 2025 and early 2026, reports of this lineage continued to emerge within surveillance systems across various regions.
The U.S. Department of Health and Human Services indicated that this data might imply that the BA.3.2 lineage was likely circulating at lower levels before routine genomic surveillance was fully established.
Symptoms of the new COVID variant
Symptoms include fever or chills, a persistent cough, fatigue, headache and muscle pain, runny nose or congestion, loss of taste or smell, nausea, vomiting, or diarrhea, and shortness of breath. A severe sore throat has been noted as one of the most prevalent indicators.
Essential Business Intelligence, Sharp Market Insights, Practical Personal Finance Advice, Daily Fuel, Gold and Silver Prices and Latest Stories — On NDTV Profit.






















